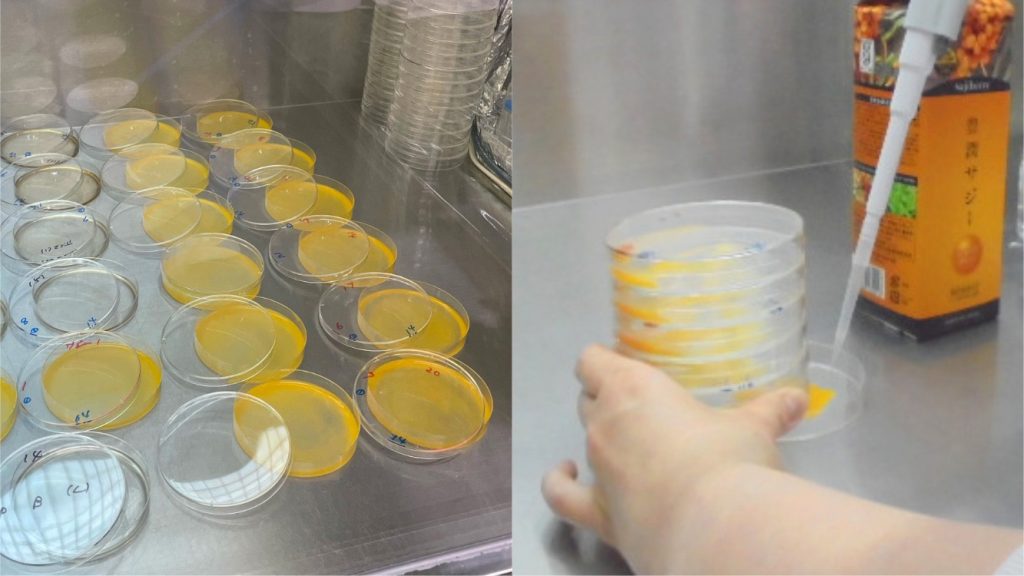

記事公開日:2023年6月6日
内モンゴルの厳しい自然環境の中で、力強く育つサジーベリー。
私たちは、その恵みを大切に収穫し、徹底した管理体制のもと製品化し、皆さまへお届けしています。
「毎日の健康に役立てていただけるよう、本当に安心できるものをお届けしたい」
――その想いから、収穫から製品化まで、一貫して品質を守り続けています。
ここからは、サジーベリーがどのようにして内モンゴルの大地から旅立ち、日本で皆さまのお手元に届くのか、その道のりを一緒にたどってみましょう。
果実の収穫
真冬の内モンゴルで、鮮やかなオレンジ色の実をつけたサジーベリーが、現地の農家の方々の手で収穫されます。
サジーベリーの枝には鋭いトゲがあるため、収穫の際は細心の注意を払いながら、実を傷めないよう丁寧に作業が行われます。
収穫されたサジーベリーは、鮮度を守るため、すぐにマイナス40℃で冷凍保存され、品質をしっかりと保ったまま次の工程へと進んでいきます。




果実の選別・洗浄
収穫されたサジーベリーは丁寧に選別され、不純物を取り除いたうえでしっかりと洗浄されます。
選び抜かれた美しい果実だけが、豊潤サジーの原料として次の工程へと進んでいきます。





サジーベリー原料の加工工場では、国際的な食品安全管理基準である「ISO22000」を取得しています。この国際基準には、HACCP(ハサップ)と呼ばれる衛生管理の仕組みが含まれており、原料の受け入れから製造・出荷まで徹底した安全管理を実施しています。
検査について詳しくはこちら
ピューレ状に加工
選び抜かれた果実は、皮ごと丁寧に裏ごしされ、遠心分離を行いきめ細かく仕上げられます。
こうして栄養素や風味をまるごと活かした、なめらかなピューレができあがります。

殺菌・輸送用に充填
できあがったピューレは、清潔な環境のもとでしっかりと殺菌されます。
その後、輸送用の容器に充填され、日本へ送られる準備に進みます。

品質検査(内モンゴル/加工工場内ラボ)
加工を終えたピューレは、日本へ輸送される前に、工場内のラボで品質検査が行われます。
厳しい品質基準をもとに、各項目をしっかりチェックし、基準を満たしたものだけが次の工程へと進みます。


検査内容:官能検査、理化学検査、微生物検査、栄養成分検査
検査について詳しくはこちら
輸入前の検査(日本/フィネスから外部機関へ依頼)
外部の専門機関へ検査を委託し、さらに詳細な品質検査を行います。
検査内容は多岐にわたり、すべての検査に合格したものだけが、日本への輸入手続きに進むことができる仕組みです。
厳格な基準を段階的にクリアすることで、「皆さまが毎日安心して飲める品質」を確保しています。


検査内容:栄養成分検査、微生物検査、残留農薬検査、清涼飲料水検査、重金属検査、放射線量測定検査
検査について詳しくはこちら
豊潤サジーに加工
日本に輸入された原料にステビアを0.1%未満ブレンドし、味を調えます。

充填・製品化
調合されたピューレは、殺菌・充填のあと冷却し、箱詰め作業へと進みます。








品質検査(充填工場内ラボ)
製品化された豊潤サジーは、充填工場内のラボで品質検査を行います。
サンプルを取り出し、味や色味に異常がないか、不純物が混入していないかを確認します。

両側の扉が同時に開かない仕組みにより、清潔で安全な状態を保っています

検査内容:官能検査、理化学検査、微生物検査
検査について詳しくはこちら
品質検査(外部の検査機関)
外部の第三者検査機関で、厳しい基準をクリアすることにより、客観的で確かな安全性が保障され安心してお召し上がりいただける状態で皆さまの元へ届けられます。



検査内容:官能検査、栄養成分検査、微生物検査、残留農薬検査、重金属検査、放射線量測定検査
検査について詳しくはこちら

配送倉庫に搬入
資料をセットし、梱包作業を行い、皆さまの元にお届けする準備を整えます。


皆さまの元へ
豊潤サジーは、皆さまに安心して続けていただけるよう、何段階もの厳しい検査と品質管理を経て完成します。
自然の力と私たちの想いが詰まった一杯が、毎日の元気や美しさにつながることを願って、これからも素材と製法にこだわりを持ち続け、変わらぬ品質と安心をお届けしてまいります。

